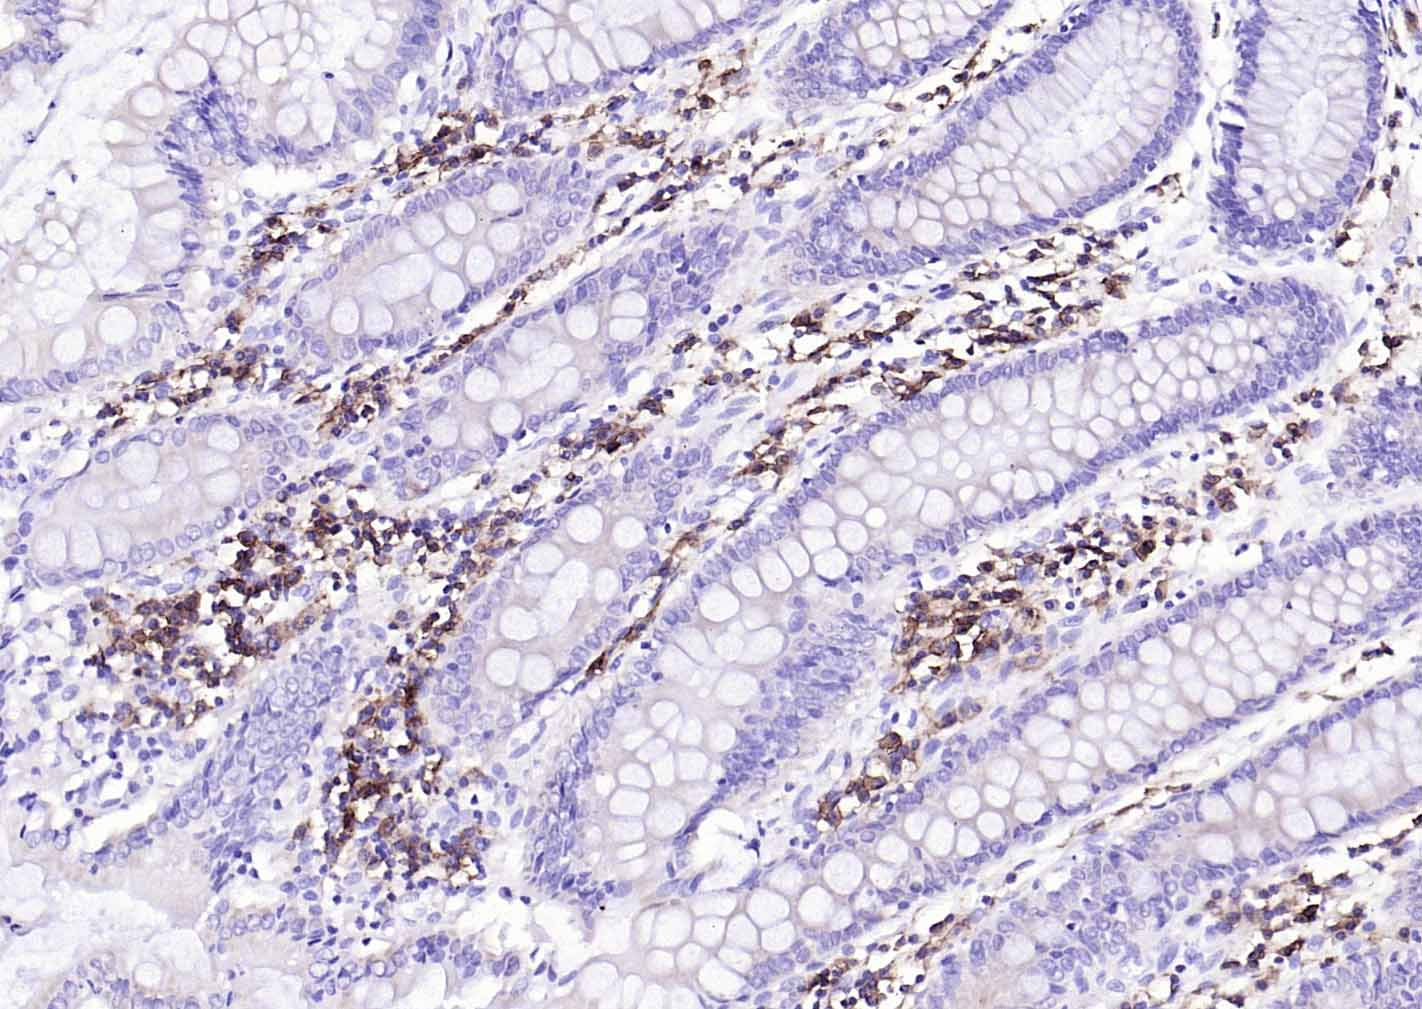
CD38单克隆抗体-bsm-34151M

CD38 Mouse mAb (一抗) - IHC-P,IHC-F,IF | Bioss

货号:bsm-34151M
产品详情
相关标记
相关产品
相关文献
常见问题
概述
产品编号
bsm-34151M
产品类型
病理级抗体、mIHC精品抗体
英文名称
CD38 Mouse mAb
中文名称
CD38单克隆抗体
英文别名
ADPRC 1; ADPRC1; cADPR1; CD38_HUMAN; CD38; 2'-phospho-ADP-ribosyl cyclase; 2'-phospho-ADP-ribosyl cyclase/2'-phospho-cyclic-ADP-ribose transferase; 2'-phospho-cyclic-ADP-ribose transferase; ADP-ribosyl cyclase 1 (ADPRC 1); Cyclic ADP-ribose hydrolase 1 (cADPR hydrolase 1); T10; 3.2.2.-; 3.2.2.6; CD38 molecule; CD38 antigen (p45); ADP-ribosyl cyclase 1; NAD(+) nucleosidase
抗体来源
Mouse
免疫原
KLH conjugated synthetic peptide derived from human CD38
亚型
IgG1, Kappa
性状
Liquid
纯化方法
affinity purified by Protein A
克隆类型
Monoclonal
克隆号
1C9
理论分子量
34 kDa
浓度
1mg/ml
储存液
Liquid in PBS containing, 0.5% BSA and 0.02% Proclin300.
研究领域
Cancer > Cancer Metabolism > Response to hypoxia
Immunology > Adaptive Immunity > B Cells > CD
Immunology > Adaptive Immunity > Regulatory T Cells
Metabolism > Pathways and Processes > Metabolism processes > Hypoxia
Metabolism > Types of disease > Cancer
Microbiology > Organism > Virus > RNA Virus > ssRNA positive strand virus > SARS Coronavirus
Stem Cells > Hematopoietic Progenitors > Hematopoietic Stem Cells > Human Lineage Negative
Stem Cells > Hematopoietic Progenitors > Lymphoid > B Lymphocytic Lineage
Stem Cells > Hematopoietic Progenitors > Lymphoid > NK Cell Lineage
Stem Cells > Hematopoietic Progenitors > Lymphoid > T Lymphocytic Lineage
Stem Cells > Hematopoietic Progenitors > Myeloid > Monocytic Lineage
SWISS
Gene ID
保存条件
Shipped at 4℃. Store at -20℃ for one year. Avoid repeated freeze/thaw cycles.
注意事项
This product as supplied is intended for research use only, not for use in human, therapeutic or diagnostic applications.
产品介绍
CD38分子是单链Ⅱ型跨膜糖蛋白,存在于很多免疫细胞表面上,CD38与无脊椎动物卵的授精、HIV感染、某些癌症以及糖尿病等有关,CD38具有许多复杂而又独特的生物学特性及功能,有调控细胞钙释放的机制。主要表达于胸腺细胞、前T和前B细胞、活化的T和B细胞、单核细胞、NK细胞、浆细胞等,可用于急性白血病的分型和活化的T细胞在自身免疫和免疫缺陷中的作用等方面的研究,也可作为生发中心B细胞的一种选择性标记。
背景资料
The protein encoded by this gene is a non-lineage-restricted, type II transmembrane glycoprotein that synthesizes and hydrolyzes cyclic adenosine 5'-diphosphate-ribose, an intracellular calcium ion mobilizing messenger. The release of soluble protein and the ability of membrane-bound protein to become internalized indicate both extracellular and intracellular functions for the protein. This protein has an N-terminal cytoplasmic tail, a single membrane-spanning domain, and a C-terminal extracellular region with four N-glycosylation sites. Crystal structure analysis demonstrates that the functional molecule is a dimer, with the central portion containing the catalytic site. It is used as a prognostic marker for patients with chronic lymphocytic leukemia. Alternative splicing results in multiple transcript variants. [provided by RefSeq, Sep 2015]

产品应用
| 应用 | 已检合格种属 | 预测种属 | 推荐稀释比例 |
|---|---|---|---|
| IHC-P | Human | 1:100-500 | |
| IHC-F | Human | 1:100-500 | |
| IF | Human | 1:100-500 |
交叉反应
交叉反应: Human
相关产品
暂无相关产品
靶标
基因名
CD38
蛋白名
ADP-ribosyl cyclase/cyclic ADP-ribose hydrolase 1
亚细胞定位
Membrane; Single-pass type II membrane protein.
组织特异性
Expressed at high levels in pancreas, liver, kidney, brain, testis, ovary, placenta, malignant lymphoma and neuroblastoma.
相似性
Belongs to the ADP-ribosyl cyclase family.
功能
Synthesizes cyclic ADP-ribose, a second messenger for glucose-induced insulin secretion. Also has cADPr hydrolase activity. Also moonlights as a receptor in cells of the immune system.
同靶标产品
相关文献
提示: 发表研究结果有使用 bsm-34151M 时请让我们知道,以便我们可以引用参考文章。作为回馈,资料提供者将获得我们送上的小礼品。